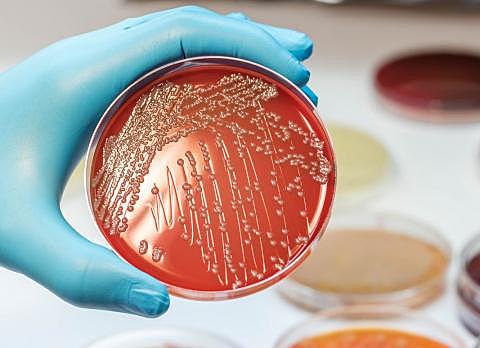
Pequeña... pero muy mala
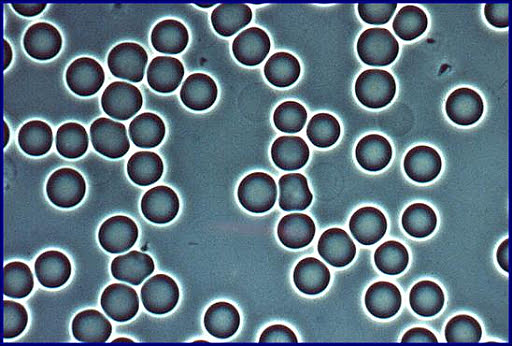
¡Están vivos!

-
Aristóteles, Tales de Mileto, Anaximandro, entre otros establecen la Teoría de la Generación Espontánea debido a la necesidad por encontrar una explicación del origen de la vida. Para ellos la vida podía surgir a partir de la nada: del lodo, de la putrefacción, del agua de mar, del rocío y de la basura, ya que ahí observaron la aparición de gusanos, insectos, cangrejos, etc. Dedujeron que esto se debía a la interacción de la materia no viva con fuerzas naturales como el calor del sol.
-
Se creía en la teoría espontánea como la responsable de enfermedades hasta que Jerónimo Fracastorius postula que la esta misma es causada por partículas vivas que van del enfermo al sano, mediante una transmisión
-
Los hermanos Janssen refuerzan la teoría de Fracastorius al construir el primer microscopio
-
Robert Hooke hace un enorme descubrimiento: observa a través del microscopio celdillas en tejido vegetal que denominó como "células"
-
Anton Van Leeuwenhoek observa microorganismos a través del microscopio a los que decide nombrar "animálculos"
-
Edward Jenner desarrolla la primera vacuna contra la viruela humana la cual causó la muerte de 60 millones de personas en Europa en el siglo XVIII.
-
Ignaz Philip Semmelweis propone el uso de antisépticos para prevenir la fiebre puerperal producida por lo que el denominaba como materia cadavérica que se encontraba en las manos de los médicos y causaba la muerte de mujeres embarazadas
-
John Snow realiza el primer estudio epidemiológico del cólera en Londres al examinar con detalle las bombas de agua de Board Street y encontrar microorganismos que causaban la muerte a personas que bebían el agua
-
Francesco Redi realiza un experimento que sacude el pensamiento de la Generación Espontánea: puso carne en unos recipientes. Unos se sellaban y los otros no, con lo que resultaban que en los recipientes sellados no aparecían moscas de la carne y en los abiertos sí. Redi llegó a la conclusión de que los gusanos aparecían en la carne descompuesta solo si las moscas habían puesto antes sus huevos en la carne: “Todo lo vivo procede de un huevo, y este de lo vivo".
-
Friedrich Miescher descubre el ADN al estudiar el esperma de trucha
-
Robert Koch descubre el Mycobacterium tuberculosis responsable de causar Tuberculosis
-
Luis Pasteur demuestra que los mohos y bacterias no se generan de forma espontánea y además se percata de que estas pueden ser eliminadas al someterlas a altas temperaturas.
-
Hans Christian Gram desarrolla la tinción de Gram al intentar aislar y observa neumococos en pulmones de pacientes que fallecían por neumonía
-
Escherich estudia los huéspedes habituales del intestino y descubre la existencia de Escherichia Coli, responsable de enfermedades del tracto digestivo
-
Serguéi Winogradski estudia las bacterias del azufre y las bacterias nitrificantes
-
Fritz Schaudinn y Erich Hoffman estudian a la espiroqueta Treponema Pallidum y la acusan como agente de causal de la sífilis
-
Frederick Twort descubre los virus bacteriófagos, virus que infectan exclusivamente a las bacterias
-
Frederick Griffith descubre el proceso de transformación bacteriana en donde las bacterias recolectan ADN de otros organismos
-
Alexander Fleming aísla a la penicilina de un cultivo de Penicillium notatum. Intentaba hacer crecer moho que terminó encontrando una sustancia en él que mataba bacterias de varias enfermedades al que llamó jugo de moho.
-
Helmut Ruska inventa el microscopio electrónico con un poder de aumento mucho más superior al del microscopio óptico.
-
Fritz Zernike desarrolla del microscopio de contraste de fases el cual permite observar células vivas sin necesidad de teñirlas y causarles la muerte.
-
Domagk descubre las sulfamidas, sustancias capaces de actuar como antibióticos y antiparasitarios que curan enfermedades infecciosas.
-
Albert Schatz aisla la estreptomicina de un cultivo de Streptomyces griseus y a pesar del intento de fraude de su maestro Selman Waksman para adjudicarse el premio Nobel, se le reconoce como el responsable original del descubrimiento.
-
Norton Zinder y joshua Lederberg descubren el fenómeno de la transducción generalizada
-
Joshua Lederberg introduce el concepto "plásmido", molécula de ADN que se encuentra en las bacterias en forma independiente al cromosoma bacteriano sin ser vital para la célula
-
James Watson y Francis Crick descubren la estructura del ADN y proponen el modelo de la doble hélice
-
Francois Jacond y Jacques Monod proponen el modelo del operón, grupo de genes estructurales cuya expresión se regula por medio de sustratos con los que interactúan las proteínas codificadas por sus genes
-
Robert W. Holley describen detalladamente el proceso aislamiento de los ARNt, donde se separa el ARN mensaje de una muestra de ARN total
-
Arber, Nathans y Smith descubren las enzimas de restricción las cuales reconocen una secuencia de nucleótidos dentro de una molécula de ADN y cortan el ADN en ese punto concreto conocido como sitio de restricción
-
Bruce Ames desarrolla el test de Ames, análisis bacteriano a corto plazo usado para determinar las substancias que causan mutaciones de gen.
-
Woese y George Fox reconocen a las archeas como tercer dominio de los seres vivos
-
Prusiner descubre el prión, proteína mal plegada que puede transmitir dicha forma a otras variedades de la misma proteína
-
B.Marshall y R. Warren descubre al Helicobacter pylori en úlceras estomacales
-
Gallo y Montangnier aislan e identifican del virus del sida
-
Kerry Mullis desarrollan la reacción en cadena de la polimerasa (PCR), técnica de laboratorio que permite amplificar pequeños fragmentos de ADN para identificar gérmenes microscópicos que causan enfermedades entre muchas otras funciones
-
Aparece la gripe aviar en China (H5N1 de Influenza tipo A)
-
Aparece un brote de gripe porcina en México (H1N1 de Influenza tipo A)
-
Aparece la gran pandemia que actualmente se sufre en todo el mundo: CoVid-19 causada por el virus SARS-CoV-2
Plan projects on a visual timeline
Map milestones, phases, deadlines, and key events in one place so the sequence is easier to see and share. Timetoast is a timeline maker for work, school, research, and stories.